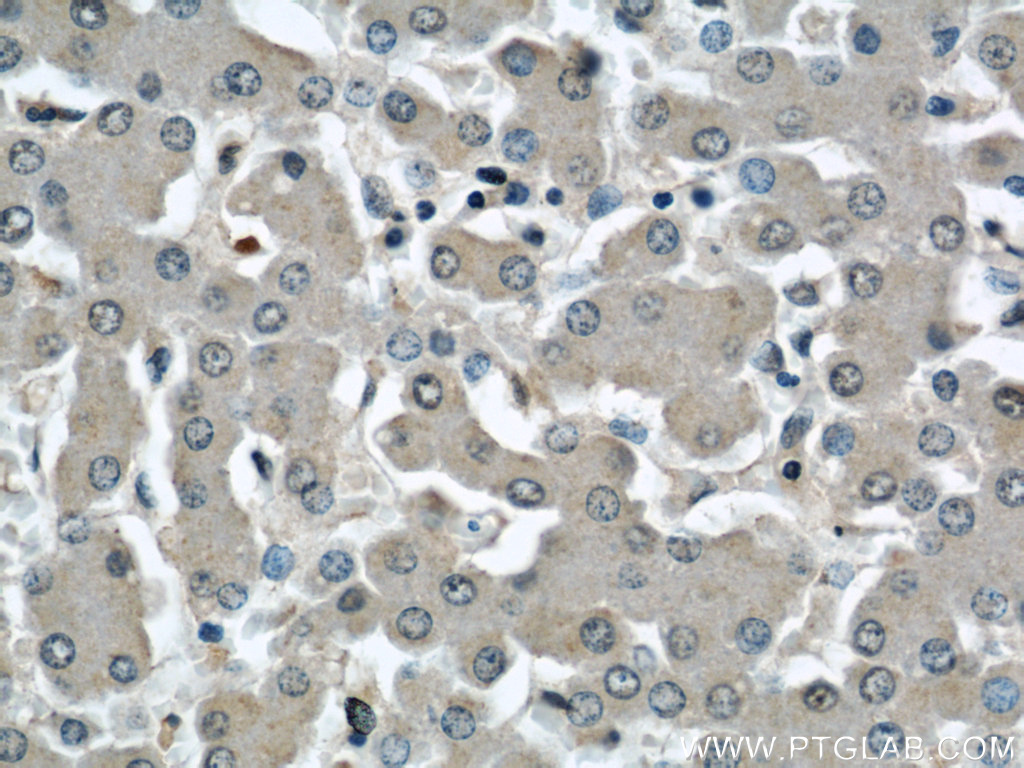

验证数据展示
经过测试的应用
| Positive WB detected in | A549 cells, HepG2 cells, SGC-7901 cells, MCF-7 cells |
| Positive IHC detected in | human liver tissue, human kidney tissue Note: suggested antigen retrieval with TE buffer pH 9.0; (*) Alternatively, antigen retrieval may be performed with citrate buffer pH 6.0 |
推荐稀释比
| 应用 | 推荐稀释比 |
|---|---|
| Western Blot (WB) | WB : 1:500-1:2000 |
| Immunohistochemistry (IHC) | IHC : 1:20-1:200 |
| It is recommended that this reagent should be titrated in each testing system to obtain optimal results. | |
| Sample-dependent, Check data in validation data gallery. | |
产品信息
22115-1-AP targets INSIG1 in WB, IF, IHC, ELISA applications and shows reactivity with human samples.
| 经测试应用 | WB, IHC, ELISA Application Description |
| 文献引用应用 | WB, IF, IHC |
| 经测试反应性 | human |
| 文献引用反应性 | human |
| 免疫原 |
CatNo: Ag17420 Product name: Recombinant human INSIG1 protein Source: e coli.-derived, PGEX-4T Tag: GST Domain: 1-90 aa of BC001880 Sequence: MPRLHDHFWSCSCAHSARRRGPPRASAAGLAAKVGEMINVSVSGPSLLAAHGAPDADPAPRGRSAAMSGPEPGSPYPNTWHHRLLQRSLV 种属同源性预测 |
| 宿主/亚型 | Rabbit / IgG |
| 抗体类别 | Polyclonal |
| 产品类型 | Antibody |
| 全称 | insulin induced gene 1 |
| 别名 | CL 6, INSIG 1, INSIG1, insulin induced gene 1, Insulin induced gene 1 protein |
| 计算分子量 | 277 aa, 30 kDa |
| 观测分子量 | 28-31 kDa, 66-70 kDa |
| GenBank蛋白编号 | BC001880 |
| 基因名称 | INSIG1 |
| Gene ID (NCBI) | 3638 |
| RRID | AB_11183051 |
| 偶联类型 | Unconjugated |
| 形式 | Liquid |
| 纯化方式 | Antigen affinity purification |
| UNIPROT ID | O15503 |
| 储存缓冲液 | PBS with 0.02% sodium azide and 50% glycerol, pH 7.3. |
| 储存条件 | Store at -20°C. Stable for one year after shipment. Aliquoting is unnecessary for -20oC storage. |
背景介绍
Insulin-induced genes (INSIGs), which consist of two isoforms (INSIG1 and INSIG2), are representative endoplasmic reticulum (ER)-resident oxysterol-binding proteins (OSBPs). INSIG1 is part of negative regulatory feedback, acting as a brake on SREBP transcriptional function (PMID: 23919961). INSIG1 also has a secondary function mediating sterolaccelerated proteolytic degradation of HMG CoA reductase, thus impacting the mevalonate pathway. Suppression of INSIG1 function promotes hepatic lipid remodelling and restrains NASH (non-alcoholic steatohepatitis) progression(PMID: 33722690).
实验方案
| Product Specific Protocols | |
|---|---|
| IHC protocol for INSIG1 antibody 22115-1-AP | Download protocol |
| WB protocol for INSIG1 antibody 22115-1-AP | Download protocol |
| Standard Protocols | |
|---|---|
| Click here to view our Standard Protocols |
发表文章
| Species | Application | Title |
|---|---|---|
Nature The gluconeogenic enzyme PCK1 phosphorylates INSIG1/2 for lipogenesis.
| ||
Transl Psychiatry A potential mechanism underlying atypical antipsychotics-induced lipid disturbances. | ||
Eur Neuropsychopharmacol Vitamin D deficiency exacerbates atypical antipsychotic-induced metabolic side effects in rats: Involvement of the INSIG/SREBP pathway. | ||
Mol Nutr Food Res (-)-Epicatechin regulates blood lipids and attenuates hepatic steatosis in rats fed high-fat diet(†). | ||
J Physiol Biochem Renal tubule ectopic lipid deposition in diabetic kidney disease rat model and in vitro mechanism of leptin intervention. | ||
JCI Insight Hypomorphic ASGR1 modulates lipid homeostasis via INSIG1-mediated SREBP signaling suppression. |